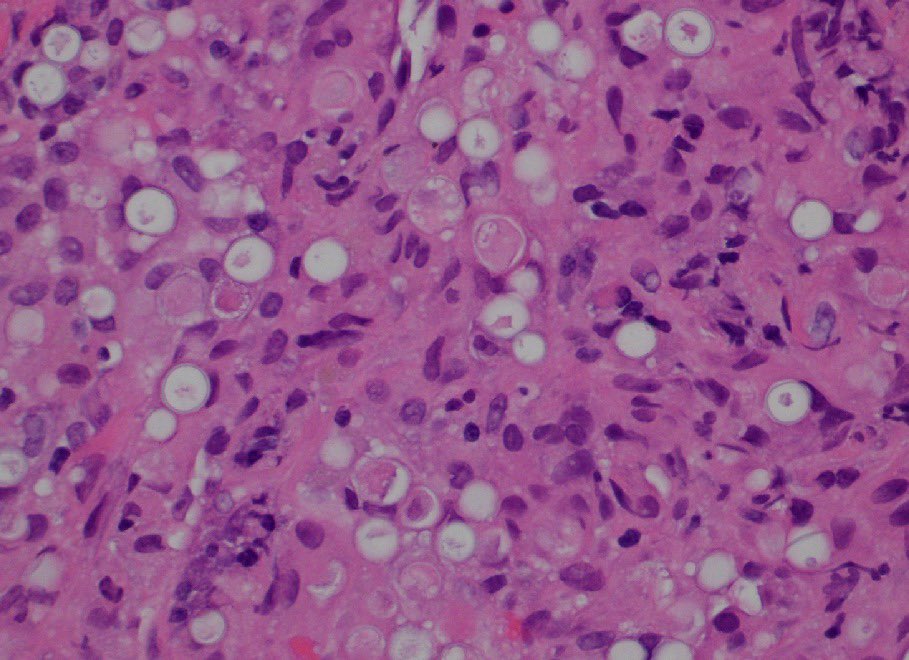
A Matloob, MD tweet media

Sabitlenmiş Tweet

"BOW TIE". Papillary thyroid carcinoma. #FNA Thyroid. #Entpath #endopath #pathology #pathtwitter #PathTweetAward @MSWPathology @MyCytopathology @SamKhader

Eesti
A Matloob, MD
744 posts

@A_MatloobMD
Head & Neck Pathology #ENTPath. Cytopathology, #FNApath